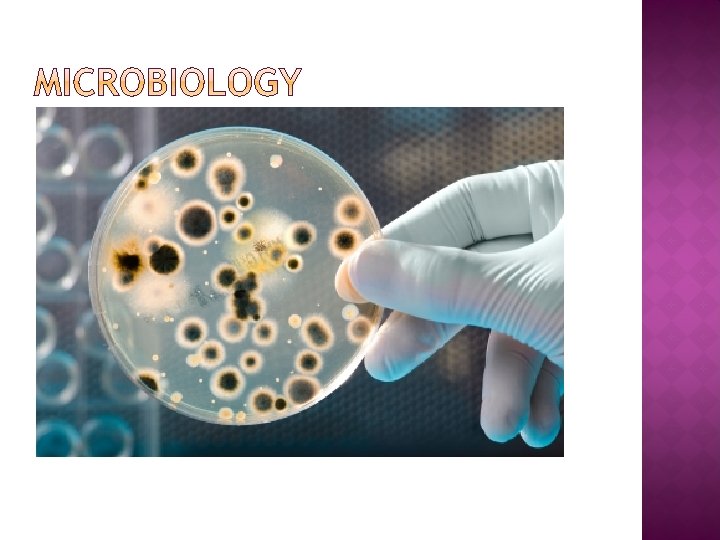

BIOLOGY FOR CLASS IX Class IX INTRODUCTION TO

BIOLOGY FOR CLASS IX

Class IX INTRODUCTION TO BIOLOGY � Content • • Definition of Biology Islamic and other views about origin of life on earth Branches Of Biology Relationship of biology with other sciences Biological Method of study Contribution Muslim and other Biologist. . Impact Of Biological Studies On Human Welfare

BIOLOGY Biology means the study of life. Biology is a Greek word. Bio mean life and logos mean study.

� We made every living thing of water. Will they not then believe? " (Surah Al-Anbiya, Ayah 30) � "And the earth have We spread out and placed there in firm hills, and caused each seemly thing to grow there in. " (Surah Al-Hijr, Ayah 19) � "Glory be to Him Who created all the sexual pairs, of that which the earth groweth, and of themselves, and of that which they know not!" (Surah Ya-sin, Ayah 36)

• Biology is very important, it tells us about the life running around us. • Biology tells us about the physical structure of living organism. • Biology help us to diagnose the diseases and find out the method of treatment. • The things biology can also tell us about is plants of major importance and what plants can help our body systems to be healthy. • Biology also helps us know the different body systems of different animals and also our selves.

� Botany -The scientific study of plants. � Zoology- The scientific study of Animals. � Microbiology- the branch of biology that deals with microorganisms and their effects on other living organisms

�Agriculture - science and practice of producing crops and livestock from the natural resources of the earth.

� Cytology-Cell Biology. The study of the structures and functions of cells and cell organelles is called cell biology. This branch also deals with the study of cell division.

� Physiology Morophology. This branch deals with the study of the structures of living organisms The study of internal structure is called anatomy.

� Anatomy - It is the branch of biology concerned with the study of the structure of organisms and their parts; with further division into animal (animals) and plant.

� Embryology. It is the study of the development of a new individual from a fertilized egg. Embryologists study the cell growth, differentiation, and morphogenesis (the process that gives rise to tissues and organs.

Ecology - the scientific study of the relationships between plants, animals, and their environment. �

�Evolutionary Biology - a subfield concerned with the origin and descent of species, as well as their change over time, i. e. their evolution

�Freshwater Biology - a science concerned with the life and ecosystems of freshwater habit ats.

� Paleontology. It is the study of fossils, which are the remains of extinct organisms. Paleontologists study the age the structure of fossils and on this basis study the process of evolution.

� Genetics - A science that deals with heredity, especially the mechanisms of hereditary transmission and the variation of inherited characteristics among similar or related organisms.

�Marine Biology - It is the study of ocean plants and animals and their ecological relationships.

� Molecular Biology - The branch of biology that deals with the formation, structure, and function of macromolecules essential to life, such as nucleic acids and proteins, and especially with their role in cell.

� Mycology - It is the study of fungi.

�Pharmacology - It is the study of preparation and use of drugs and synthetic medicines

� Physiology - the biological study of the functions of living organisms and their parts.

� Biology is a multi dimensional science. It is linked with the Knowledge of chemistry, physics, Mathematics, sociology etc. 1. Biochemistry: It tell us about the synthesis of bimolecular structure. biochemistry to explain the synthesis of bimolecular, their requirement and the effect caused by the deficiency and efficiency of different molecules on the organisms and their metabolism.

� In this branch We apply laws and techniques of physics to explain the metabolism of living organism in order to find out the age of fossils. e. g C. T scane, X-ray etc BIOMETRY: Biometry is used in data and measurements related to living organisms are dealt with. BEHAVIORAL BIOLOGY : Many of the facts of biology are reflected in the study of behavior it is an intersection of biochemistry, genetics, physiology.

� The study of behavior, especially social behavior, also associates biology to the social sciences and humanities.

� The method which is used to solve the Problem in the field of biology by observation, data collection and experimentation is called biological method. 1. Observation(find out the problem) 2. Hypothesis(it is the guess) 3. Deduction(Logical production) 4. Experiment(it is show the practical test) 5. Result(+ve or –ve) 6. Law or Theory

� The history of biology goes back to the ancient and pre historic time. � knowledge of biology occurred during the Greek period. � Aristotle (322 -384 B. C) wrote a book "Historia Animalia". � Carolus Linnaeus founder of biological classification, classified animals into two units i. e. genus and species.

� From the 8 th to the 15 th century, Muslims studied Greek and other literature, translated books of Roman and Sanskrit into Arabic, wrote new books and opened numerous centers of learning. � The most outstanding contribution of Muslim scientists had been the use of experiments for the first time in scientific study.

� modest list of contributions by the Muslim and other scientists between the 8 th and 20 th century.

� Jabir-Bin-Hayan (722 -817 A. D), wrote books named "Al-Nabatat" and "Al-Haywan" on plants and animals respectively � Muslims have made important contributions in the field of biology in earlier ages.

� Abdul Malik Asmai (741 A. D), wrote books "Alkheil, "Al-wahoosh", and "khalaqul Insan", describing structure and function of body parts of horses, camels, sheep, wild animals and human being. "Khalaqul Insan" was popular among the western experts in Zoology.

� Ali bin Rabban Tubri (775 -870 A. D), wrote book "Firdus-ul-Hikma" having many designs and detailed articles on Philosophy, Zoology, Psychology and Astronomy.

� Abu-Usman Umer Aljahiz, wrote book "Al. Haywan" which described � characteristics of 350 species of animals especially, about life of ants.

� Al-Farabi (870 -950 A. D) and Abul-Qasim Al Zahravi (936 -1004 A. D). Both were the renowned hakim and surgeon of the Islamic World. Al Farabi is the author of two very well known books i. e. "Kitab-Nabatat" and "Kitab-ul-Haywanat" and Zahravi was famous for the removal of urinary bladder stone

� Ibn-al Haitham (965 -1039 A. D), wrote books like "Kitabul Manazir" and "Mizanul-Hikma", He explained the phenomenon of vision and corrected the Greek conception about vision.

� Bu-Ali Sina (980 A. D), wrote books "Al. Qanoon" and "Fil Tib Al-Shifa", about plants, animals and non-living things. He is considered as one of the founder of medicine, acknowledged by the greatest expert of his time in medicines in east and west.

Other Biologists: � After 15 th century, European and other biologists made important contribution in the field of Biology. � William Harvey (1578 -1657 A. D), described circulation of blood.

� Galileo (1610) invented microscope to examine small organisms

� Charles Darwin (1859), wrote his famous book "origin of species" about evolution of different species through Natural selection

� Biology provide help to improving quality of life. � It also helped in increasing food production and to improve health. � biology are bringing revolution in medicine, agriculture, dentistry, veterinary medicine, Production of food, Improvement of health

� "He is the Creator of the heavens and the earth". (Surah Al'Ana'm, Ayah 102) � “We did create man from an essence of clay” (Surah Al- mominoon, Ayah 12) “ Then shaped we the drop a clot, then fashioned we the clot a little lump, then fashioned we the little lump bones, then clothed the bones with flesh” (Surah almominoon, Ayah 14)

� The principle that living organisms develop o nly from other living organisms and not from nonliving matter. � The original evolution of life or living organisms from inorganic or inanimate substances. .
- Slides: 42